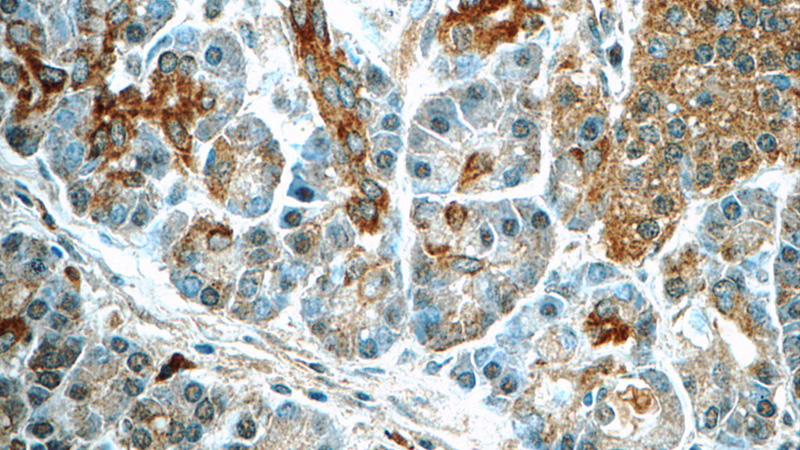
SERPINB10 Rabbit Polyclonal antibody

Serpin peptidase inhibitor, clade B (ovalbumin), member 10 is a protein that in humans is encoded by the SERPINB10 gene.
Function
The superfamily of high molecular weight serine proteinase inhibitors (serpins) regulate a diverse set of intracellular and extracellular processes such as complement activation, fibrinolysis, coagulation, cellular differentiation, tumor suppression, apoptosis, and cell migration. Serpins are characterized by a well-conserved tertiary structure that consists of 3 beta sheets and 8 or 9 alpha helices. A critical portion of the molecule, the reactive center loop connects beta sheets A and C. Protease inhibitor-10 (PI10; SERPINB10) is a member of the ov-serpin subfamily, which, relative to the archetypal serpin PI1, is characterized by a high degree of homology to chicken ovalbumin, lack of N- and C-terminal extensions, absence of a signal peptide, and a serine rather than an asparagine residue at the penultimate position.
References
Further reading
This article incorporates text from the United States National Library of Medicine, which is in the public domain.